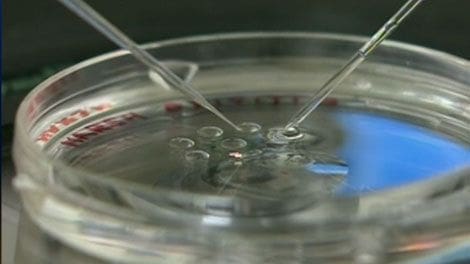
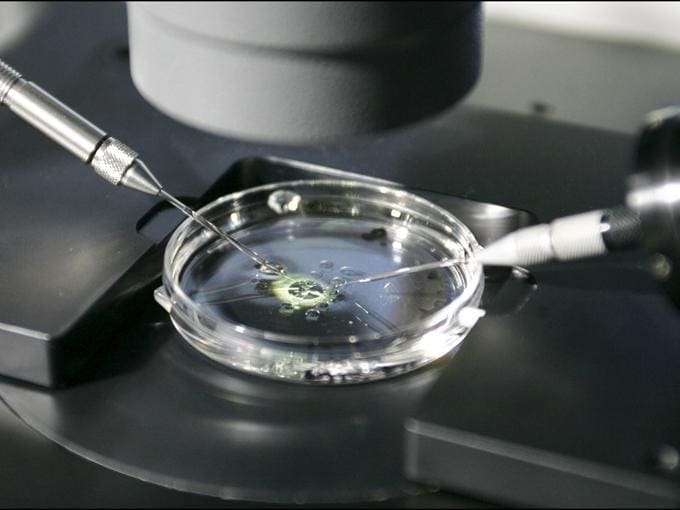

Dr. Adolfo de Prados
Tratamientos para la baja reserva ovárica: Opciones y expectativas
La baja reserva ovárica es una condición que puede afectar la fertilidad femenina, caracterizada por una reducción en la cantidad y presumiblemente la calidad de los óvulos disponibles en los […]
SABER MÁS